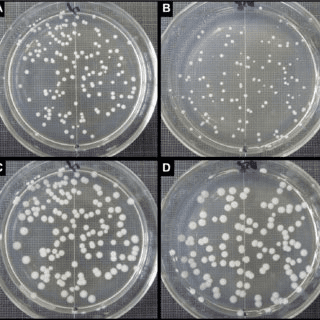
Petri dish showing bacterial colonies, with transformed bacteria growing on antibiotic-containing medium while non-transformed bacteria fail to grow

Why Biotechnology is Changing Your World Right Now
Have you ever wondered how scientists created a COVID-19 vaccine in record time? Or how farmers grow crops that can survive droughts? The answer lies in biotechnology-one of the most exciting and rapidly evolving fields in modern science.
Think about this: the insulin that saves millions of diabetic lives worldwide is now produced by bacteria in laboratories. Sounds like science fiction, right? But it’s very real, and it’s happening because scientists learned to “reprogram” living organisms at the genetic level.
In this comprehensive guide, we’ll explore IGCSE Biology Topic 21-Biotechnology and Genetic Modification. Whether you’re preparing for your 0610 exam or simply curious about how scientists are reshaping life itself, you’re in the right place. We’ll break down complex concepts into bite-sized pieces, use real-world examples, and give you the exam strategies you need to ace this topic.
Let’s dive into the fascinating world where biology meets technology!
What Exactly is Biotechnology?
The Simple Definition
Biotechnology is the use of living organisms, or parts of living organisms, to make useful products or solve practical problems. It’s essentially using biology as a technology platform.
Think of it this way: for thousands of years, humans have been using yeast to make bread rise and bacteria to turn milk into yogurt. That’s biotechnology in its traditional form! But modern biotechnology takes this concept to an entirely new level by manipulating the genetic code itself.
Traditional vs Modern Biotechnology
Traditional Biotechnology (been around for centuries):
- Brewing beer using yeast fermentation
- Making cheese and yogurt using bacterial cultures
- Baking bread with yeast
- Producing soy sauce through fermentation
Modern Biotechnology (the cutting-edge stuff):
- Genetic engineering and modification
- Producing human insulin in bacteria
- Creating genetically modified crops
- Gene therapy for treating diseases
- Cloning organisms
- DNA fingerprinting for forensics
The key difference? Modern biotechnology involves directly manipulating DNA-the instruction manual of life itself.
Understanding Genetic Engineering: The Core Concept
What is Genetic Engineering?
Genetic engineering (also called genetic modification or GM) is the process of deliberately changing an organism’s genetic material by adding, removing, or altering specific genes.
Imagine you have a cookbook (DNA) with thousands of recipes (genes). Genetic engineering allows scientists to:
- Copy a recipe from one cookbook to another
- Delete recipes that cause problems
- Edit recipes to make them work better
- Insert brand new recipes from completely different sources
Why Do We Need Genetic Engineering?
The applications are genuinely life-changing:
- Medicine: Producing insulin, growth hormones, and vaccines
- Agriculture: Creating pest-resistant crops, drought-tolerant plants
- Industry: Manufacturing enzymes, biofuels, biodegradable plastics
- Research: Understanding diseases, developing treatments
- Environment: Creating bacteria that clean up oil spills
The Genetic Engineering Process: Step-by-Step
This is crucial for your exam, so pay close attention! The process involves several key steps and important biological tools.
Step 1: Identifying and Isolating the Desired Gene
First, scientists must locate the specific gene they want to transfer. This gene could be:
- The human insulin gene (from human DNA)
- A gene for pest resistance (from bacteria)
- A gene for herbicide tolerance (from various sources)
How it’s done:
- Scientists use their knowledge of genetics to locate genes on chromosomes
- They identify the DNA sequence that codes for the desired protein
- Special enzymes help “cut out” this gene
Step 2: Using Restriction Enzymes (Molecular Scissors)
Restriction enzymes (also called restriction endonucleases) are the molecular scissors of genetic engineering.
Key points about restriction enzymes:
- They cut DNA at specific sequences called recognition sites
- Different restriction enzymes recognize different DNA sequences
- They create “sticky ends”-short, unpaired DNA sequences that can bond with complementary sequences
- These sticky ends are crucial because they allow DNA from different sources to join together

Example: The restriction enzyme EcoRI recognizes the sequence GAATTC and cuts between G and A on both strands, creating complementary sticky ends.
Step 3: Isolating a Vector (The Delivery Vehicle)
A vector is a carrier molecule used to deliver the foreign gene into the target organism. Think of it as a biological delivery truck.
Common vectors include:
- Plasmids (most common):
- Small, circular DNA molecules found naturally in bacteria
- Separate from the main bacterial chromosome
- Can replicate independently
- Easy to manipulate and transfer
- Viruses:
- Used in gene therapy
- Naturally good at inserting DNA into cells
Why plasmids are perfect vectors:
- Small and easy to work with
- Contain genes for antibiotic resistance (useful for selection)
- Can be easily inserted into bacterial cells
- Replicate when bacteria divide
Step 4: Cutting the Vector with the Same Restriction Enzyme
Here’s the clever part: scientists use the same restriction enzyme that cut out the desired gene to cut open the plasmid vector.
Why is this important?
- Both the gene and the plasmid have complementary sticky ends
- These matching sticky ends allow them to bond together
- It’s like having two jigsaw puzzle pieces that fit perfectly

Step 5: Joining Gene and Vector Using Ligase
DNA ligase is the molecular glue that seals the gene into the vector.
The process:
- The sticky ends of the gene and plasmid base-pair together
- DNA ligase enzyme forms permanent bonds between the sugar-phosphate backbones
- The result is recombinant DNA-DNA that contains genes from two different sources
Recombinant DNA = Vector DNA + Foreign gene
This is a revolutionary moment: you’ve created a DNA molecule that nature never made!

Step 6: Inserting Recombinant DNA into Host Cells
Now we need to get our engineered plasmid into living cells (usually bacteria like E. coli).
Methods include:
- Transformation (most common):
- Bacterial cells are treated with calcium chloride or heat shock
- This makes their cell membranes temporarily permeable
- Plasmids can slip through the membrane
- Only some bacteria take up the plasmid
- Electroporation:
- Electric pulses create temporary pores in cell membranes
- Plasmids enter through these pores
Important note: Not all bacteria take up the plasmid-typically only 1-10% are successfully transformed.
Step 7: Identifying Successfully Modified Cells
This is where antibiotic resistance genes on the plasmid become crucial!
The selection process:
- The plasmid contains a gene for antibiotic resistance (e.g., ampicillin resistance)
- All bacteria (transformed and non-transformed) are grown on agar plates containing that antibiotic
- Only bacteria with the plasmid survive-they’re resistant!
- Bacteria without the plasmid die-they’re killed by the antibiotic
- Survivors are cultured to produce millions of copies
Step 8: Expression of the Desired Gene
Once inside the host bacteria:
- The foreign gene is “expressed”-it’s read and transcribed into mRNA
- The mRNA is translated into the desired protein
- The bacteria now produce the foreign protein (e.g., human insulin)
- The bacteria are cultured in large fermenters
- Millions of bacteria = millions of protein factories!
The beauty of this system:
- Bacteria reproduce rapidly (every 20 minutes under ideal conditions)
- One bacterium becomes millions overnight
- All carry and express the human gene
- They produce vast quantities of the desired protein
Real-World Application: Producing Human Insulin
Let’s see genetic engineering in action with one of its greatest success stories!
The Problem Before Genetic Engineering
Before 1982, diabetic patients relied on insulin extracted from:
- Pig pancreases (porcine insulin)
- Cow pancreases (bovine insulin)
Issues with animal insulin:
- Slightly different amino acid sequence from human insulin
- Could cause allergic reactions in some patients
- Required slaughtering thousands of animals
- Expensive and limited supply
- Slight differences in effectiveness
The Solution: Genetically Engineered Bacteria
The process:
- Gene identification: Scientists isolated the human insulin gene from human DNA
- Gene insertion: The gene was inserted into bacterial plasmids
- Bacterial transformation: E. coli bacteria were transformed with the recombinant plasmids
- Selection: Antibiotic resistance markers identified successful transformations
- Production: Bacteria were cultured in industrial fermenters
- Harvesting: Human insulin was extracted and purified
The result:
- Pure human insulin-identical to what your pancreas makes
- No allergic reactions
- Unlimited supply
- More affordable
- No animals harmed
This was revolutionary! It proved that genetic engineering could produce life-saving medicines safely and effectively.

Genetically Modified Organisms (GMOs) in Agriculture
This is where biotechnology becomes controversial but also incredibly practical. Let’s explore both sides objectively.
What Are GM Crops?
Genetically modified crops are plants whose DNA has been altered to give them specific beneficial characteristics that wouldn’t naturally occur through traditional breeding.
Common Genetic Modifications in Crops
1. Herbicide Resistance
- What it is: Crops engineered to survive specific herbicides
- Example: Roundup Ready soybeans resist glyphosate herbicide
- How it works: A gene from bacteria allows the plant to produce an enzyme that breaks down the herbicide
- Benefit: Farmers can spray entire fields to kill weeds without harming crops
2. Pest Resistance
- What it is: Crops that produce their own insecticide
- Example: Bt cotton and Bt corn
- How it works: A gene from Bacillus thuringiensis (Bt) bacteria produces a protein toxic to specific insects
- Benefit: Reduces need for chemical pesticides, protecting beneficial insects
3. Disease Resistance
- Example: Papaya resistant to ringspot virus
- Benefit: Saved the Hawaiian papaya industry from complete collapse
4. Enhanced Nutrition
- Example: Golden Rice
- What it is: Rice genetically modified to produce beta-carotene (vitamin A precursor)
- Why it matters: Could prevent vitamin A deficiency in developing countries, which causes blindness and death in children
5. Improved Shelf Life
- Example: Flavr Savr tomato (first GM food approved)
- How it works: Gene for ripening enzyme was silenced
- Benefit: Tomatoes stay fresh longer, reducing food waste
6. Drought Tolerance
- What it is: Crops that need less water
- Benefit: Crucial for climate change adaptation and water-scarce regions
Comparison of GM crops
| GM Crop | Modification | Gene Source | Benefit |
|---|---|---|---|
| Bt Cotton | Insect resistance | Bacillus thuringiensis | Reduces pesticide use by 50-80% |
| Golden Rice | Vitamin A production | Daffodil + bacteria | Prevents vitamin A deficiency |
| Roundup Ready Soy | Herbicide resistance | Bacteria | Easier weed control |
| Papaya | Virus resistance | Virus coat protein | Saved Hawaiian papaya industry |
Advantages of Genetic Modification
For Farmers and Food Production
- Higher Crop Yields
- Pest-resistant crops suffer less damage
- More food from the same land area
- Crucial for feeding growing global population (expected to reach 10 billion by 2050)
- Reduced Pesticide Use
- Bt crops need fewer chemical sprays
- Better for the environment
- Safer for farmworkers
- Reduces costs for farmers
- Lower Production Costs
- Less money spent on pesticides and herbicides
- More efficient farming
- Can benefit small-scale farmers in developing countries
- Crop Growth in Challenging Conditions
- Drought-tolerant crops in dry regions
- Salt-tolerant crops in coastal areas
- Cold-resistant crops in cooler climates
For Human Health and Nutrition
- Enhanced Nutritional Content
- Golden Rice addresses vitamin A deficiency
- Iron-enriched crops combat anemia
- Potential to create “functional foods” with health benefits
- Production of Medicines
- Insulin, growth hormone, clotting factors
- Potentially cheaper medications
- More reliable supply
- Reduced Food Prices
- More efficient production = lower costs
- Important for food security in developing nations
For the Environment
- Reduced Chemical Use
- Fewer pesticides = less environmental pollution
- Reduced pesticide runoff into water systems
- Protection of beneficial insects like bees
- Reduced Soil Erosion
- Herbicide-resistant crops allow no-till farming
- Soil structure preserved
- Better carbon sequestration
Concerns and Disadvantages of Genetic Modification
It’s essential to understand both sides of this debate. These are legitimate concerns that scientists and regulators take seriously.
Environmental Concerns
- Gene Transfer to Wild Relatives
- The concern: GM crops might cross-pollinate with wild plants
- Potential problem: Creating “superweeds” resistant to herbicides
- Reality check: Scientists create “buffer zones” and use sterile seeds to prevent this
- Harm to Non-Target Organisms
- The concern: Bt crops might harm beneficial insects
- Example: Early studies suggested monarch butterfly larvae might be affected
- Current evidence: Later studies showed minimal real-world impact when properly managed
- Reduced Biodiversity
- The concern: Widespread use of few GM varieties reduces genetic diversity
- Why it matters: Less diversity = greater vulnerability to new diseases
- Counter-argument: This is a problem with modern agriculture generally, not just GM crops
- Development of Resistant Pests
- The concern: Insects might evolve resistance to Bt toxin
- Solution: “Refuge strategies” where some non-GM crops are planted to slow resistance development
Health Concerns
- Potential Allergic Reactions
- The concern: New proteins might cause allergies in some people
- Safety measures: All GM foods are extensively tested for allergenicity before approval
- Reality: No confirmed cases of allergic reactions from approved GM foods
- Unknown Long-Term Effects
- The concern: We don’t know the long-term health impacts
- Counter-argument: GM foods have been consumed since 1996 with no documented health problems
- The debate: Some argue this isn’t long enough to know for certain
- Antibiotic Resistance Markers
- The concern: Antibiotic resistance genes used in selection might transfer to bacteria in our gut
- Scientific consensus: Risk is extremely low; modern GM crops often use alternative markers
Ethical and Economic Concerns
- Corporate Control of Food Supply
- The concern: Few large companies own most GM seed patents
- Issues: Farmers must buy new seeds each year; loss of traditional seed-saving practices
- Impact on developing nations: Dependency on foreign corporations
- Ethical Objections
- Religious concerns: Some believe genetic modification is “playing God”
- Natural food preference: Many prefer “natural” unmodified foods
- Animal welfare: Concerns about GM animals
- Labeling and Consumer Choice
- The debate: Should GM foods be labeled?
- Pro-labeling: Consumers have a right to know
- Anti-labeling: Might unfairly stigmatize safe products
Other Important Applications of Biotechnology
Gene Therapy
What it is: Treating genetic diseases by replacing faulty genes with functional ones.
Potential applications:
- Treating cystic fibrosis
- Correcting inherited blindness
- Fighting certain cancers
- Treating sickle cell anemia
The process:
- Functional gene is inserted into a viral vector
- Vector delivers gene to patient’s cells
- Cells begin producing the correct protein
Status: Several gene therapies have been approved; many more in clinical trials
DNA Fingerprinting (Genetic Profiling)
What it is: Using DNA analysis to identify individuals
Applications:
- Forensic science: Identifying criminals from DNA at crime scenes
- Paternity testing: Determining biological parenthood
- Identifying disaster victims: When other identification isn’t possible
- Conservation: Tracking endangered species populations
How it works:
- DNA is extracted from a sample (blood, hair, saliva)
- Specific regions with high variability between individuals are analyzed
- Pattern of DNA fragments is unique to each person (except identical twins)
Cloning
What it is: Creating genetically identical copies of an organism
Types:
- Reproductive cloning: Creating a whole organism (like Dolly the sheep)
- Therapeutic cloning: Creating embryonic stem cells for medical research
The process (reproductive cloning):
- Nucleus removed from body cell of animal to be cloned
- Nucleus removed from egg cell
- Body cell nucleus inserted into empty egg cell
- Egg develops into embryo
- Embryo implanted into surrogate mother
Famous example: Dolly the sheep (1996)—first mammal cloned from adult cell
Current status:
- Technique works but is inefficient
- Many ethical concerns about human cloning
- Useful for preserving endangered species
Regulation and Safety Testing of GMOs
It’s crucial to understand that GM products undergo extensive testing before approval.
The Approval Process
1. Laboratory Development (2-5 years)
- Gene identification and insertion
- Initial testing in controlled conditions
2. Greenhouse Trials (1-2 years)
- Testing under controlled environmental conditions
- Assessing plant growth and trait expression
3. Field Trials (3-4 years)
- Small-scale outdoor tests
- Monitoring environmental interactions
- Assessing crop performance
4. Safety Assessment (1-2 years)
- Compositional analysis (proteins, nutrients)
- Toxicity testing
- Allergenicity testing
- Environmental impact assessment
5. Regulatory Review
- Government agencies review all data
- Public comment periods
- Decision on approval
Total time: Typically 10-15 years and costs $100-150 million
Who Regulates GMOs?
International:
- Codex Alimentarius Commission (food standards)
- Cartagena Protocol on Biosafety (international movement)
United States:
- FDA (food safety)
- EPA (environmental impact)
- USDA (agricultural considerations)
European Union:
- European Food Safety Authority (EFSA)
- Very strict approval process
Key point for exams: GM products are among the most thoroughly tested foods in human history.
Fermentation: Traditional Biotechnology
Don’t forget this important topic! Fermentation is biotechnology’s foundation.
What is Fermentation?
Fermentation is the process where microorganisms (bacteria, yeast, fungi) break down organic substances, typically in the absence of oxygen (anaerobic respiration).
Types of Fermentation You Need to Know
1. Alcoholic Fermentation (by yeast)
Equation:
Glucose → Ethanol + Carbon dioxide + Energy
C₆H₁₂O₆ → 2C₂H₅OH + 2CO₂ + Energy (ATP)
Applications:
- Making beer, wine, spirits
- Bread making (CO₂ makes bread rise)
- Bioethanol fuel production
Conditions for optimal yeast fermentation:
- Temperature: 25-30°C (too hot kills yeast; too cold slows activity)
- pH: Slightly acidic (pH 4-6)
- Sugar availability
- Anaerobic conditions (for alcohol production)
2. Lactic Acid Fermentation (by bacteria)
Equation:
Glucose → Lactic acid + Energy
C₆H₁₂O₆ → 2C₃H₆O₃ + Energy (ATP)
Applications:
- Yogurt production (Lactobacillus bacteria)
- Cheese making
- Sauerkraut and kimchi (pickled vegetables)
- Muscle cells during intense exercise (produces lactic acid causing muscle fatigue)
Industrial Fermenters
Large-scale fermentation happens in fermenters (also called bioreactors).
Key features of industrial fermenters:
- Temperature control: Heating/cooling jacket maintains optimal temperature
- pH monitoring and control: Sensors and addition of acids/bases
- Oxygen supply: Air pump and stirrer for aerobic processes
- Stirring mechanism: Ensures even distribution of nutrients and microorganisms
- Nutrient inlet: For adding culture medium
- Sterile conditions: Prevents contamination by unwanted microorganisms
- Product harvest outlet: For removing products
Products made in fermenters:
- Antibiotics (penicillin)
- Insulin and other hormones
- Single-cell protein (SCP) for animal feed
- Enzymes for industry
- Vitamins
- Organic acids
Quick Revision: Key Points to Remember
Genetic Engineering Process
Step 1: Isolate desired gene using restriction enzymes
Step 2: Cut vector (plasmid) with same restriction enzyme
Step 3: Join gene to vector using DNA ligase (creates recombinant DNA)
Step 4: Insert recombinant DNA into host cell (transformation)
Step 5: Select successfully modified cells using antibiotic resistance
Step 6: Culture cells to produce desired protein
Essential Definitions
- Biotechnology: Using living organisms to make useful products
- Genetic engineering: Deliberately changing an organism’s genetic material
- Vector: DNA molecule used to carry foreign gene into host cell
- Restriction enzyme: Cuts DNA at specific recognition sites
- DNA ligase: Joins DNA fragments together
- Recombinant DNA: DNA containing genes from different sources
- GMO: Organism whose genetic material has been artificially modified
Fermentation Equations
Alcoholic fermentation:
Glucose → Ethanol + Carbon dioxide + Energy
Lactic acid fermentation:
Glucose → Lactic acid + Energy
Advantages of GM Crops
- Higher yields
- Pest resistance
- Herbicide tolerance
- Enhanced nutrition
- Reduced pesticide use
- Climate adaptation
Disadvantages/Concerns
- Environmental risks (gene transfer, biodiversity loss)
- Health concerns (allergies, long-term effects)
- Ethical issues (corporate control, “playing God”)
- Economic dependency
Memory Tips and Mnemonics
For the genetic engineering process, remember “I CUT THINGS”:
- Isolate gene
- Cut with restriction enzyme
- Use vector (plasmid)
- Treat with same enzyme
- Tie together with ligase
- Host cell transformation
- Identify successful cells
- New protein production
- Grow cultures
- Select with antibiotics
For restriction enzymes: Think “molecular SCISSORS” – they cut DNA at specific sites
For DNA ligase: Think “molecular GLUE” – it sticks DNA pieces together
For fermentation: “YEAST makes ALCOHOL, BACTERIA makes YOGURT” (Y=A, B=Y)
Common Mistakes to Avoid
1: Confusing Restriction Enzymes and Ligase
Wrong: “Ligase cuts DNA”
Right: Restriction enzymes cut; ligase joins
2: Forgetting the Role of Sticky Ends
Remember: Sticky ends from the same restriction enzyme are complementary—that’s why they can bond!
3: Missing the Selection Step
Don’t forget: Not all bacteria take up the plasmid; antibiotic resistance helps identify successful transformations
4: Thinking All GMOs Are Crops
Remember: GMOs include bacteria producing insulin, GM animals, and microorganisms for industrial processes
5: Confusing Fermentation Types
Key difference:
- Yeast → Alcohol + CO₂
- Bacteria → Lactic acid only
6: Forgetting Conditions for Fermentation
Always mention: Temperature, pH, oxygen availability (or lack thereof), nutrients
Test Yourself: Practice Questions
Short Answer Questions
Question 1: Explain the role of restriction enzymes in genetic engineering. (3 marks)
Sample Answer:
Restriction enzymes cut DNA molecules at specific recognition sequences (1 mark). They create sticky ends-short single-stranded DNA sections (1 mark). These sticky ends allow DNA from different sources to join together because they have complementary base sequences (1 mark).
Question 2: Why is the same restriction enzyme used to cut both the desired gene and the plasmid vector? (2 marks)
Sample Answer:
Using the same restriction enzyme ensures that both the gene and plasmid have complementary sticky ends (1 mark), which allows them to base-pair together and be joined by DNA ligase (1 mark).
Question 3: Describe how bacteria that have successfully taken up recombinant plasmids are identified. (3 marks)
Sample Answer:
The plasmid contains a gene for antibiotic resistance, such as ampicillin resistance (1 mark). All bacteria are grown on medium containing the antibiotic (1 mark). Only bacteria with the plasmid survive because they have resistance; bacteria without the plasmid die (1 mark).
Question 4: State two advantages and two disadvantages of producing genetically modified crops. (4 marks)
Sample Answer:
Advantages:
- Higher crop yields due to pest resistance (1 mark)
- Reduced pesticide use, better for environment (1 mark)
Disadvantages:
- Potential harm to non-target organisms (1 mark)
- Risk of genes transferring to wild relatives creating superweeds (1 mark)
Extended Response Questions
Question 5: Describe the process of using genetic engineering to produce human insulin in bacteria. (6 marks)
Sample Answer Framework:
- Isolate human insulin gene using restriction enzymes
- Cut plasmid vector with same restriction enzyme
- Join gene to plasmid using DNA ligase (recombinant DNA)
- Transform E. coli bacteria with recombinant plasmid
- Select successful bacteria using antibiotic resistance
- Culture bacteria in fermenters; they produce human insulin
Question 6: Explain how Bt cotton has been genetically modified to resist insect pests and discuss one advantage and one concern about its use. (5 marks)
Sample Answer Framework:
- Gene from Bacillus thuringiensis bacteria inserted into cotton DNA
- Gene codes for protein toxic to certain insect larvae
- Cotton plants produce the Bt toxin in their tissues
- Insect pests die when they eat the plant
- Advantage: Reduces need for chemical pesticides
- Concern: Risk of insects developing resistance to Bt toxin
Question 7: Compare and contrast alcoholic fermentation and lactic acid fermentation. (6 marks)
Sample Answer Framework:
Similarities:
- Both anaerobic respiration processes
- Both start with glucose
- Both produce energy (ATP)
- Both used in food production
Differences:
- Alcoholic: produces ethanol + CO₂; done by yeast
- Lactic acid: produces lactic acid only; done by bacteria
- Alcoholic: used for beer/wine/bread; Lactic acid: used for yogurt/cheese
Important Equations Box
Fermentation Equations
Alcoholic Fermentation (Yeast):
C₆H₁₂O₆ → 2C₂H₅OH + 2CO₂ + Energy
Glucose → Ethanol + Carbon dioxide + Energy (small amount of ATP)
Lactic Acid Fermentation (Bacteria):
C₆H₁₂O₆ → 2C₃H₆O₃ + Energy
Glucose → Lactic acid + Energy (small amount of ATP)
Key Point: Both produce much less energy than aerobic respiration because glucose is only partially broken down.
Exam Tips for Topic 21
What Examiners Look For
- Accurate use of scientific terminology
- Use terms like “restriction enzyme,” “vector,” “recombinant DNA” correctly
- Don’t say “restriction enzyme glue” (that’s ligase!)
- Understanding of sequences and processes
- Genetic engineering steps must be in correct order
- Understand WHY each step happens, not just WHAT happens
- Balanced evaluation
- When asked about GM crops, give BOTH advantages AND disadvantages
- Use specific examples, not vague statements
- Correct equations
- Know fermentation equations precisely
- Include all products (don’t forget CO₂ in alcoholic fermentation!)
- Application of knowledge
- Be ready to apply your knowledge to unfamiliar scenarios
- Example: “A plant has been genetically modified to produce vitamin C. Describe how this could be done.”
Command Words to Watch
- State/Name: Just give the fact (1-2 words usually)
- Describe: Say what happens in sequence
- Explain: Say what happens AND why
- Compare: Give similarities AND differences
- Evaluate/Discuss: Give advantages, disadvantages, and maybe a conclusion
Time Management
- Topic 21 questions usually worth 5-10 marks total in Paper 2
- Spend about 1 minute per mark
- Long answer questions (6 marks): plan your answer in bullet points first
Real-World Connections: Why This Matters
The COVID-19 Vaccine Connection
The mRNA vaccines for COVID-19 (Pfizer and Moderna) represent cutting-edge biotechnology:
- Used genetic engineering principles to create mRNA that codes for viral spike protein
- Fastest vaccine development in history (less than 1 year!)
- Shows how biotechnology saves lives in real-time
Climate Change and GM Crops
As climate change increases droughts, floods, and temperature extremes:
- GM crops resistant to these stresses become crucial
- Could mean the difference between food security and famine
- Your generation will see biotechnology become even more important
The Future of Medicine
Biotechnology is revolutionizing healthcare:
- Personalized medicine based on your genetic code
- Gene editing technologies like CRISPR
- Lab-grown organs for transplants
- Cancer treatments tailored to tumor genetics
The knowledge you’re learning now is the foundation for understanding tomorrow’s breakthroughs!
Summary: The Big Picture
Biotechnology is the intersection of biology and technology, where we use living organisms or their components to make useful products or solve problems.
Key concepts to remember:
- Genetic engineering allows us to transfer specific genes between organisms, creating GMOs with desired characteristics
- The process involves restriction enzymes (cut), vectors (carry), DNA ligase (join), transformation (insert), and selection (identify)
- Applications include medicine (insulin production), agriculture (GM crops), industry (fermenters), and forensics (DNA fingerprinting)
- Fermentation is traditional biotechnology using microorganisms to produce products like alcohol, yogurt, and bread
- Benefits include higher crop yields, medical advances, and environmental improvements
- Concerns involve environmental risks, health questions, and ethical considerations
- Regulation ensures GMOs are thoroughly tested before approval
This technology is shaping our world RIGHT NOW, and understanding it gives you insight into some of the most important debates in science and society.
Words of Encouragement
Biotechnology might seem complex at first-and honestly, it is! You’re learning about cutting-edge science that’s actively reshaping our world. But here’s the secret: every expert started exactly where you are now.
Break down the content into small chunks. Master the genetic engineering process step-by-step. Understand one GM crop example really well before moving to others. Use the mnemonics. Draw the diagrams multiple times until they’re automatic.
This topic is not just about passing your IGCSE exam (though you’ll absolutely ace it!). It’s about understanding the technology that’s curing diseases, feeding billions, and solving global challenges. You’re learning the language of the future.
You’ve got this!
Every time you review these concepts, they become clearer. Every practice question you attempt builds your confidence. And when you walk into that exam hall, you’ll have the knowledge and understanding to tackle any question they throw at you.
Remember: biotechnology is changing the world, and now you understand how. That’s pretty amazing.
Recommended –